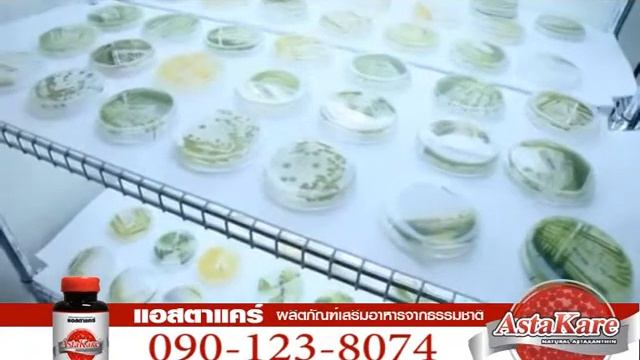
AstaKare (แอสตาแคร์) ดูแลสุขภาพ PV1.1 смотреть онлайн

Автор / Канал: Радостные исследования Страница 8

Creative Cocktail Ice Satisfying#29

28102 Indigo Lake Ct

DRAYTON RESERVOIR - 48HRS ON PEG 21 AND PEG 22

Гражданская оборона - Тоталитаризм

Fanaa - Ishq Mein Marjawan | फना - इश्क में मरजावां | Ep. 98 & 99 | Recap

Endoform – Natural & Antimicrobial Dermal Template

GRID METERING AMR | FEEDER METERING | 66/33/11KV FEEDER METERING | FEEDER CATEGORIZATION

Coupling reaction with aniline everything depends on the pH medium

SHOREGALAN 2014 | Nomineringsvideo

Bimbel UKOM Kebidanan 19:15 WIB (09/08/2021)

【悲報】清宮、日ハムで陰湿なイジメにあっていた・・・ 【2ch】ニュー速クオリティより

опа эндермен

прохожу уровень the platform by:NukeForcex

Перебиты, поломаны крылья.

QUE ES Y PARA QUE SIRVE IMMUNOCAL CANCER, DIABETES, INSUFICIENCIA RENAL, VIH, HIGADO, RIÑONES.
AstaKare (แอสตาแคร์) ดูแลสุขภาพ PV1.1

Sajim Kahan

Хайриддини Бозор туйёна базми вахдати 2022

Рыба из золотой воды Марьяна Дятьково

Analysis of mixture of organic compounds| mixture of benzoic acid and benzophenone|Knowledge academ

Key Tempo Change

#mc menor vx 》《perdoe amor💑❤ ~₩dj nunca men vi 😁😂😂

Forever Lord You Reign Led by Pastor Saki | LoveWorld Singers

French Defense: Winawer Variation, Retreat Variation | Blitz | Titled Chess
За каждым успешным каналом стоит личность, идея и сотни часов кропотливого труда. Если вы здесь, значит, автор «Радостные исследования» уже сумел зацепить ваше внимание своим уникальным стилем или подачей. А мы на RUVIDEO позаботились о том, чтобы вы могли изучить весь архив его работ в максимально комфортных условиях — без лишней суеты и преград.
Почему за работами канала «Радостные исследования» так интересно наблюдать? Всё просто: это честный контент, который находит отклик в сердцах зрителей. На нашем ресурсе вы можете смотреть онлайн все видео любимого автора бесплатно и в хорошем качестве. Нам важно, чтобы вы видели каждую деталь и слышали каждый нюанс, поэтому мы используем только стабильные плееры из открытых источников Rutube.
Следите за новинками канала, пересматривайте старые шедевры и открывайте для себя новые грани творчества «Радостные исследования». Мы постоянно обновляем ленту, чтобы у вас под рукой всегда были самые свежие выпуски. Никаких сложных регистраций — только вы и творчество, которое вдохновляет. Приятного вам путешествия по миру авторского контента на RUVIDEO!
Видео взято из открытых источников Rutube. Если вы правообладатель, обратитесь к первоисточнику.